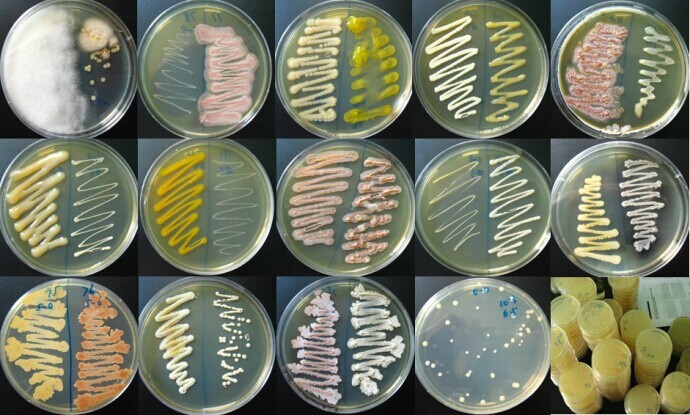
菌种扩繁

订单提交后,10分钟内,我们将安排工作人员和您联系!
江苏科检检测技术有限公司
电话:18326618418
邮箱:
地址:南京市鼓楼区
微生物多样性分析是研究微生物群落组成、结构和功能多样性的过程,它对于理解生态系统功能、疾病发生机制、环境质量评估等众多领域都具有关键作用。**一、多样性的概念及层次**1. 物种多样性 - 这是微生物多样性最直观的层次,包括微生物群落中物种的丰富度(即物种的数目)和均匀度(各物种个体数目分配的
18326618418 立即咨询微生物多样性分析是研究微生物群落组成、结构和功能多样性的过程,它对于理解生态系统功能、疾病发生机制、环境质量评估等众多领域都具有关键作用。
**一、多样性的概念及层次**
1. 物种多样性
- 这是微生物多样性最直观的层次,包括微生物群落中物种的丰富度(即物种的数目)和均匀度(各物种个体数目分配的均匀程度)。例如,在一个土壤微生物群落中,存在多种细菌、真菌和放线菌等微生物种类,丰富度高说明物种数目多;如果各物种的个体数量相对接近,均匀度就高。
2. 基因多样性
- 微生物基因库的多样性反映了微生物在遗传物质层面的差异。即使是同一种微生物,不同菌株之间的基因序列也可能存在差异,这些差异可能导致它们在生理功能、适应性等方面的不同。例如,在细菌的耐药基因方面,不同菌株可能携带不同的耐药基因,从而影响其对药物的反应。
3. 功能多样性
- 指微生物群落所具备的各种生理功能的多样性。微生物在生态系统中发挥着多种功能,如物质循环(碳循环、氮循环等)、能量转换、污染物降解等。例如,有些微生物能够分解复杂的有机物质,将其转化为无机物质,参与土壤肥力的形成;而有些微生物可以进行光合作用,将光能转化为化学能。
**二、分析方法**
1. 基于培养的方法
- 传统的微生物培养方法可以用于微生物多样性分析,但这种方法存在局限性,因为在自然环境中只有一小部分微生物可以被培养。不过,对于可培养的微生物,通过选择不同的培养基和培养条件,可以分离和鉴定出不同种类的微生物。
- 例如,使用选择性培养基可以分离出特定类型的微生物,如含有高浓度盐的培养基可以筛选出耐盐微生物;通过生化鉴定试验(如糖发酵试验、酶活性测试等)对分离得到的微生物进行分类和鉴定,从而了解微生物的多样性。
2. 分子生物学方法
- 基因指纹图谱技术:
- 变性梯度凝胶电泳(DGGE)和温度梯度凝胶电泳(TGGE):原理是基于DNA序列的差异导致其在变性剂浓度或温度梯度凝胶中的迁移率不同。从微生物群落中提取总DNA,然后对特定基因(如16S rRNA基因)进行PCR扩增,将扩增产物在梯度凝胶中电泳。不同的DNA序列会在凝胶中形成不同的条带,这些条带可以反映微生物群落的多样性。
- 随机扩增多态性DNA(RAPD):使用随机引物对微生物基因组DNA进行PCR扩增,由于不同微生物基因组DNA序列的差异,扩增产物的大小和数量会不同,产生的多态性图谱可以用于分析微生物群落的多样性。
- 高通量测序技术:
- 16S rRNA基因测序:16S rRNA基因在细菌和古菌中高度保守且具有一定的可变区域,通过对16S rRNA基因进行高通量测序,可以获得大量微生物的基因序列信息。对这些序列进行生物信息学分析,如聚类分析、分类注释等,可以了解微生物群落的物种组成和多样性。例如,通过比较不同环境样本中的16S rRNA基因序列,可以确定哪些微生物种类在特定环境中占优势,以及环境变化对微生物群落结构的影响。
- 宏基因组测序:直接对环境样本中的全部微生物基因组进行测序,不仅可以分析微生物的物种多样性,还可以深入挖掘微生物的基因和功能多样性。通过组装和注释测序数据,可以发现新的微生物基因和代谢途径,全面了解微生物群落的功能潜力。
3. 生物信息学分析
- 数据预处理:对于高通量测序数据,首先需要进行质量控制,包括去除低质量的序列、去除接头序列等。然后进行序列聚类,将相似的序列归为一类,通常采用的算法有UPGMA(非加权组平均法)、邻接法等。
- 多样性指数计算:通过计算多样性指数来量化微生物多样性。常用的物种多样性指数有Shannon - Wiener指数、Simpson指数等。Shannon - Wiener指数考虑了物种的丰富度和均匀度,值越高表示多样性越高;Simpson指数主要侧重于优势种的作用,值越低表示多样性越高。
- 分类注释和功能预测:利用数据库(如NCBI的nr数据库、KEGG代谢通路数据库等)对序列进行分类注释,确定微生物所属的物种或分类单元。同时,可以通过软件工具(如PICRUSt)基于16S rRNA基因序列数据预测微生物群落的功能,了解微生物在生态系统中的潜在作用。
**三、应用领域**
1. 生态系统研究
- 在土壤生态系统中,微生物多样性分析可以揭示土壤微生物在土壤肥力形成、植物生长促进、碳氮循环等过程中的作用。例如,研究发现某些根际微生物的多样性与植物的生长状况密切相关,通过调节微生物多样性可以提高土壤质量和农作物产量。
- 在水生生态系统中,分析微生物多样性有助于了解水体的生态健康状况。例如,水体污染可能导致微生物多样性降低,通过监测微生物多样性的变化可以评估水质和生态修复的效果。
2. 医学领域
- 人体微生物组研究是微生物多样性分析的重要应用领域。通过分析人体肠道、口腔、皮肤等部位的微生物多样性,了解微生物群落与人体健康和疾病的关系。例如,肠道微生物多样性的改变与炎症性肠病、肥胖症、糖尿病等多种疾病密切相关,这些研究为疾病的诊断、治疗和预防提供了新的思路。
3. 环境监测与修复
- 在环境监测中,微生物多样性可以作为环境质量的生物指标。例如,在污染土壤或水体的修复过程中,监测微生物多样性的变化可以评估修复措施的有效性。微生物的多样性恢复通常意味着生态系统功能的改善和环境质量的提高。

整体微生物实验是一个综合的过程,涵盖了从微生物的采集、培养、鉴定到各种生理生化特性研究以及应用探索等多个环节。以下是一个较为完整的微生物实验流程及内容介绍: ···...
菌种扩繁是微生物学研究和应用中一项关键的技术,它是指在合适的条件下,让微生物菌种大量繁殖,以满足后续实验、生产或保存等需求。以下是关于菌种扩繁的详细介绍: ···...

